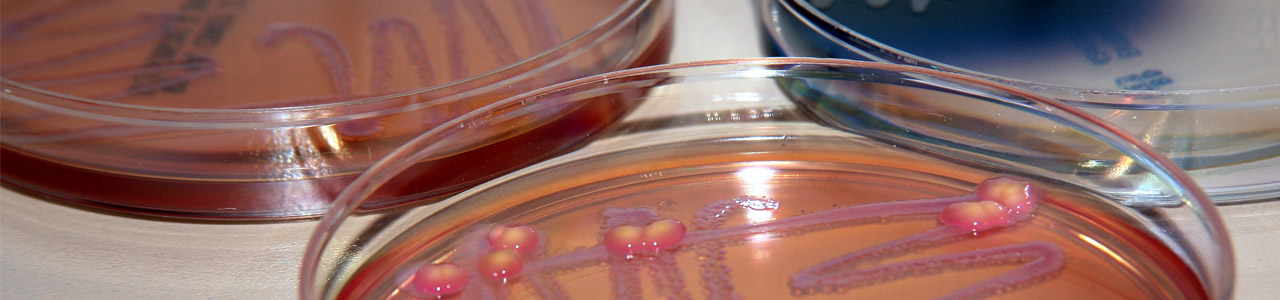

Zubehör
Eine Besonderheit ist die M&S Aufrollpinzette. Mit ihrer Hilfe können Membranfilter nach der Filtration sehr einfach zusammengerollt und durch enghalsige Flaschen in Flüssigmedien überführt werden.
Die ideale Ergänzung zu den Nährkartonscheiben sind die Ampullen mit 3,5ml sterilem Wasser. Sie enthalten genau das erforderliche Volumen, um die Nährkartonscheiben optimal zu befeuchten. Der dabei entstehende Überschuss an Flüssigkeit ist erforderlich, um die bei der Inkubation verdunstende Menge Wasser zu ergänzen und die Nährkartonscheibe feucht zu halten. Nur so wird sichergestellt, dass die gelösten Nährstoffe den Zellen auf der Membranoberfläche zum Wachstum zur Verfügung stehen.
Eine weitere Möglichkeit, NKS mit sterilem Wasser zu befeuchten, bietet der Einsatz einer Selbstfüller-Dosierspritze. Sie ist stufenlos bis maximal 5 ml einstellbar und besitzt einen Luer-Lock-Anschluss, an den ein steriler Spritzenvorsatzfilter aufgedreht werden kann. So wird bei jedem Hub steriles Wasser in dem eingestellten Volumen auf die Kartonscheibe dosiert und gleichzeitig über einen Schlauch aus einem Vorratsgefäß Wasser in die Spritze nachgefüllt. Ideal bei einer großen Anzahl von Proben.
Petrischalen mit einem Durchmesser von 60 mm zum Ausgießen von Agar, autoklavierbare Flaschen und Röhrchen und eine handliche UV-Lampe für den Fluoreszenz-Nachweis, z.B. bei den ECD-MUG-NKS oder den Cetrimid-Nährboden runden das M&S Zubehör-Sortiment ab.
| Zubehör | Beschreibung | Artikelnummer |
|---|---|---|
| M&S Petrischalen | steril, AD Deckel: 60 mm, ID Boden: 55 mm, H: 12 mm, 500 Stück | 6060-500 |
| Dosierspritze | Volumen stufenlos bis 5 ml einstellbar, selbstfüllend, Luer-Lock-Anschluss, autoklavierbar | 6100 |
| Steriles Wasser | 5 x 10 Ampullen mit je 3,5 ml zur Benetzung der Nährkartonscheiben | 6105 |
| UV-Lampe | Wellenlänge 366 nm für ECD-Methode, komplett mit Batterie | 6110 |